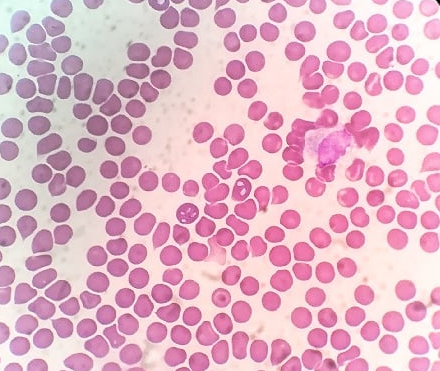

Health info sheet
The piroplasmosis
The piroplasmosis
is due to a microscopic parasite
seen in dog red blood cells. Very common in our region, it is transmitted by tick bites. The tick is contaminated during a blood meal on an affected dog. The females lay eggs and then die. The infected eggs give rise to larvae, nymphs and then adults which, by biting another dog, transmit the disease to it.
The lifestyle of individuals plays a role in the frequency of contamination:
hunting dogs, dogs living outside, frequent walks in rural areas.
There are also two seasonal peaks: spring fall. However, we often encounter cases of piroplasmosis in our patients at the beginning of January.
The presence of this parasite in the blood leads to the destruction of Red cells.
The first symptom is often an unexplained depression, a sad dog.
We also observe thehyperthermia, a loss of appetite, of the pale mucous membranes, sometimes yellow, a large spleen, dark urine, sometimes coffee-colored. Severe complications can occur: kidney failure, coagulation disorders.
The first symptom is often an unexplained depression, a sad dog.
We also observe thehyperthermia, a loss of appetite, of the pale mucous membranes, sometimes yellow, a large spleen, dark urine, sometimes coffee-colored. Severe complications can occur: kidney failure, coagulation disorders.
Demonstration of the parasite under the microscope on a fblood rottis
confirms the presence of piroplasmosis.
On the other hand, the absence of a visible parasite does not make it possible to exclude piroplasmosis. There are more sophisticated detection techniques (PCR) but with a waiting period to get the result.
The treatment aims to eliminate the parasite (injection of imidocarb) but also to treat or prevent any complications (corticosteroid therapy, infusion if necessary, sometimes transfusion in extreme cases).
Even if there is a vaccine against piroplasmosis (2 injections 1 month apart then a booster every 6 months or every year depending on the dog's lifestyle), prevention comes first and foremost through the use of anti -ticks.
It will be necessary to choose the solution best suited to each animal according to its lifestyle, its exposure to parasitic risk (tablets, pipettes, necklaces) respecting the modes of use and in particular the renewal frequencies.
Even if there is a vaccine against piroplasmosis (2 injections 1 month apart then a booster every 6 months or every year depending on the dog's lifestyle), prevention comes first and foremost through the use of anti -ticks.
It will be necessary to choose the solution best suited to each animal according to its lifestyle, its exposure to parasitic risk (tablets, pipettes, necklaces) respecting the modes of use and in particular the renewal frequencies.